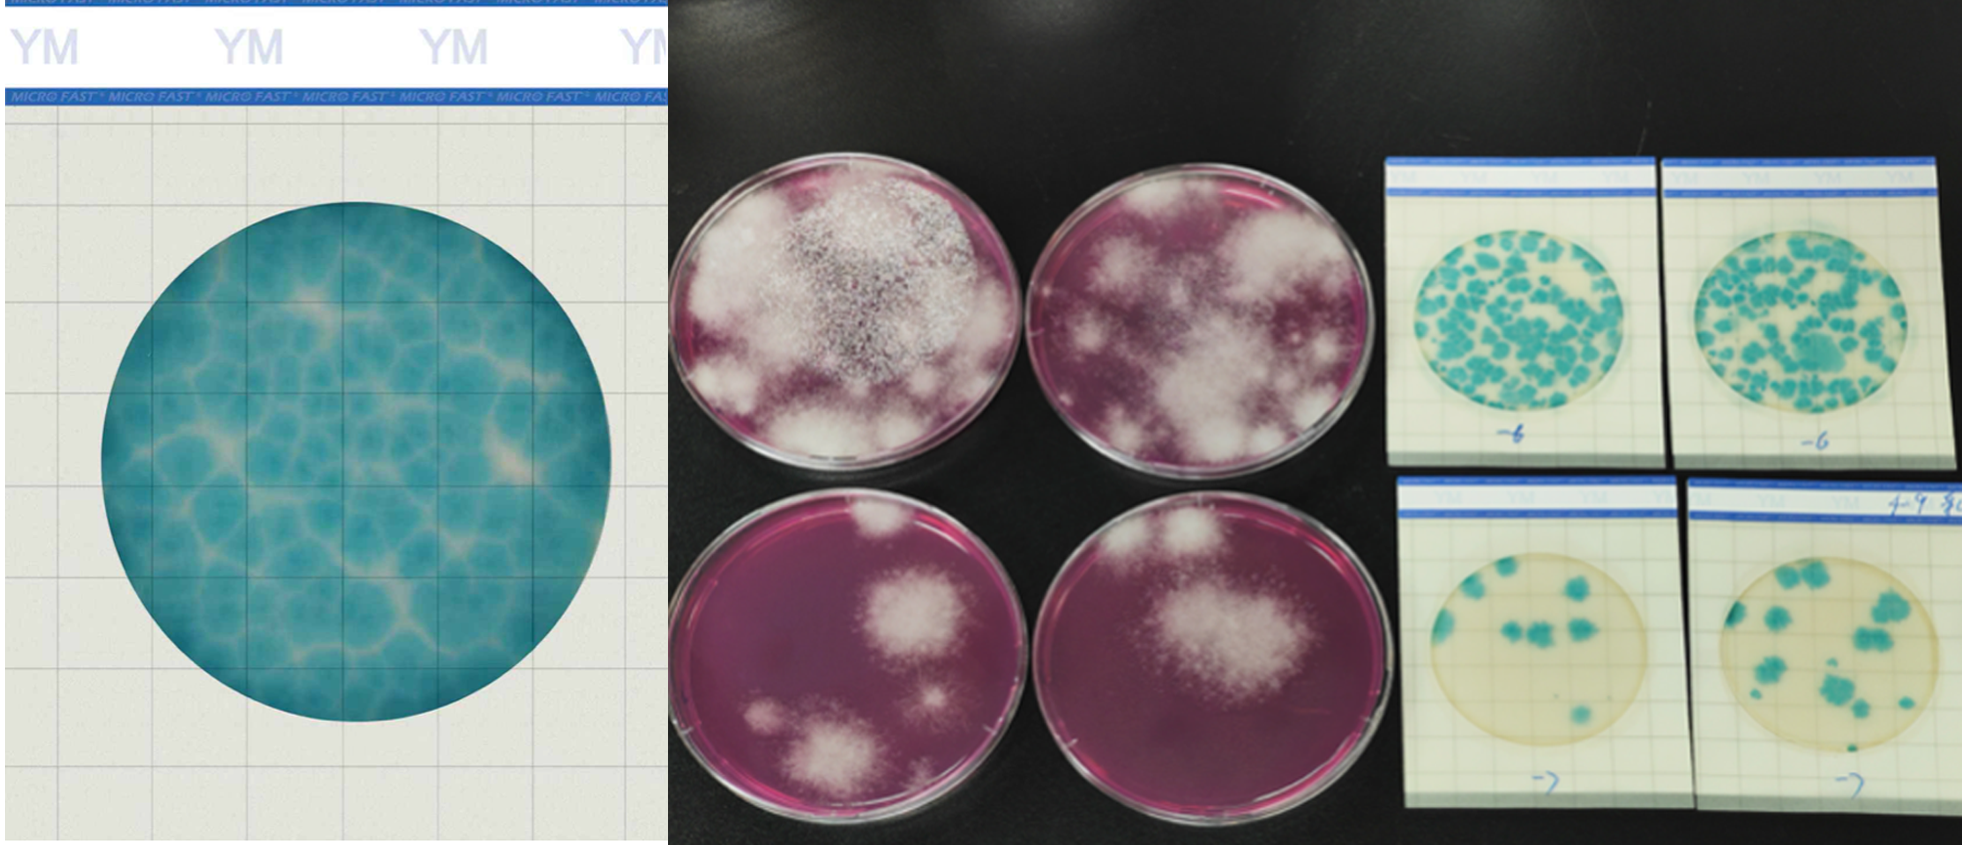
ceshipian.png

2025-06-19 10:32浏览量:250
2025年梅雨季节被称之为10年不遇的最早梅雨季,今年的梅雨季"来得早、下得猛",对食品加工企业的生产过程挑战蛮大的,尤其是南方的企业。水分活度达到0.7以上,大部分霉菌就能快速生长。霉菌酵母污染防控也显得尤为重要。
环境温湿度升高导致车间微生物控制难度增加(特别是烘干、冷却、灌装、包装区域)。原材料(特别是淀粉类、牛奶、坚果类)更易在采购、运输、暂存过程中带菌或增加初始含菌量。
PART.01 霉菌酵母容易污染的食品
◉ 高糖/高渗透压食品(果酱、蜂蜜、糖浆、干果等)
◉ 水分含量高的新鲜果蔬
◉ 发酵食品
◉ 乳制品(酸奶、奶酪等)
◉ 谷物及坚果
◉ 烘焙食品与面包、蛋糕
◉ 饮料与果汁等
PART.02 霉菌酵母检测的几大痛点
第一痛点“检测周期长”,仓储压力增加,降低货架期,无法快速纠偏。
第二痛点“霉菌孢子污染”,无论正置培养还是倒置培养,操作不到位都会造成孢子污染。正置培养,如果倾注培养基的温度高了,平皿的上盖有泠凝水,在培养过程中冷凝水滴落到培养基上,也极容易造成菌落蔓延,平皿也会污染。而倒置污染会带来孢子的次生污染,进而影响检测结果准确性。
第三痛点“霉菌蔓延,无法准确计数”,由于污染问题,或者部分霉菌生长过快等原因而造成的菌落蔓延,无法准确计数。
第四痛点“热损伤”,倾注温度偏高,对样品中的菌会造成热损伤,检测结果偏低。
PART.03 美正霉菌酵母测试片如何助力实验室解决痛点?
美正霉菌酵母测试片法建立的核心目标在于助力食品企业有效降低食品安全风险。 为此,该方法的制定聚焦于提升检测结果的时效性与可靠性:
(1)加快产品放行速度: 可实现 48h 快速判读,通过快速检测缩短样品检测时间。
(2)建立标准化检测流程: 覆盖不同食品基质(如需要膜过滤的样品、常规样品、生物酶活性较高样品等),提高实验室效率。
(3)控制实验室环境风险: 测试片自身的结构优势可有效降低操作过程中的霉菌孢子污染。
(4)提高结果准确性与重现性: 即用培养基,可有效避免热损伤;显色清晰“有边界”,可有效解决培养基上霉菌蔓延无法计数的痛点,提高结果的准确性。
这些措施的共同目标是构建更高效、标准化的质控环节,从而帮助企业及早识别风险,快速纠偏,保障食品品质安全。
PART.04 建立方法,并经过了充分的方法验证
(1)方法开发实验室:参照ISO16140-2和AOAC通则,进行50+株目标菌和30+株非目标菌测试;并进行了10大类+基质在不同污染水平下的准确度和相对正确度验证,稳健性验证(可预期的、较小幅度的、合理的偏差的指标,如温度、培养时间等)。
(2)第三方实验室验证:产品上市之前,有SGS参照ISO16140-2进行准确度和相对正确度验证。
验证结果:在相对正确度方面150个样品中超出差值的总平均值的95%置信区间的样品个数为5个,比例为1:30,满足ISO16140-2:2016中要求的不得高于1:20的比例;在准确度方面所验证的5个食品类型的β-期望容忍区间均在可接受性限值范围内, 均符合ISO 16140-2:2016对于方法等效性的要求。
对于低污染水平的饮料产品,采取膜过滤的方式进行处理,分别用 MicroFast®霉菌酵母菌测试片和GB 4789.15-2016的方法进行测试,两个方法对于霉菌酵母菌的检出情况一致符合要求。
(3)协同实验室间验证:3家实验室提供的共计90个测试结果数据,根据 ISO 16140-2:2016对数据进行统计分析,乳制品、粮食制品、坚果及籽类制品在低、中、高三个不同污染水平的准确度上均符合实验室间验证要求;饮料产品在低浓度污染水平采用膜过滤的方法,其准确度也符合 ISO 16140-2:2016中对实验室间验证的结果要求。

(4)国际认证:AOAC-PTM认证进行中,参照AOAC通则,开展包容性、排他性、方法一致性、稳健性等参数研究。已经完成方法开发实验室和独立实验室验证,等待审核出证。
上一篇: 荔枝季:别让 “甜蜜陷阱” 坑了你!
下一篇: 真菌毒素检测仪品牌美正生物2025年